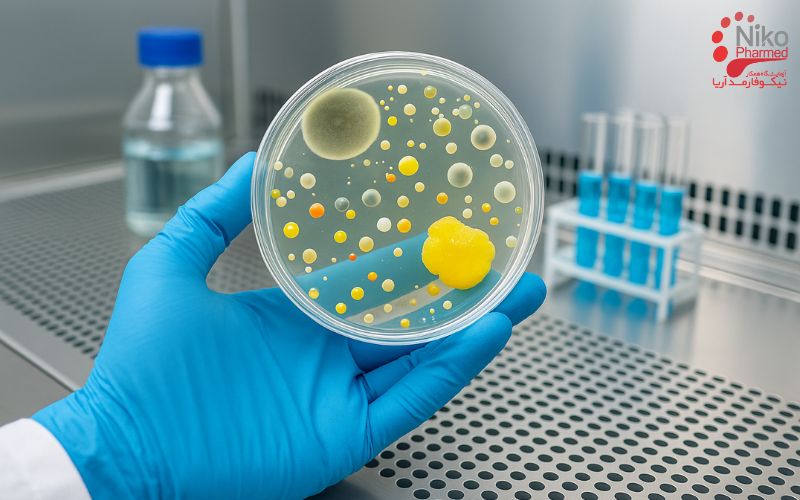
آزمون چالش میکروبی (Challenge Test)

آزمون چالش میکروبی (Challenge Test) چیست؟
آزمون چالش میکروبی طبق استاندارد ISO 11930 روشی برای ارزیابی اثربخشی سیستم نگهدارنده (Preservative System) در محصولات آرایشی و بهداشتی است تا مقاوت محصول در برابر آلودگیهای میکروبی ارزیابی شود.
در آزمون چالش میکروبی (Challenge Test)، نمونه بهصورت کنترلشده با مجموعهای از میکروارگانیسمهای شاخص مانند Staphylococcus aureus، Escherichia coli، Pseudomonas aeruginosa، Candida albicans و Aspergillus brasiliensis تلقیح میشود و سپس کاهش جمعیت میکروبی در فواصل زمانی مشخص اندازهگیری میشود.
میزان کاهش بر اساس معیارهای پذیرش A و B در استاندارد سنجیده میشود تا مشخص شود سیستم نگهدارنده توان کافی برای جلوگیری از رشد یا نابودی میکروارگانیسمها دارد یا خیر. این آزمون بخشی حیاتی از کنترل کیفیت و ایمنی میکروبی محصولات آرایشی است و نتایج آن نقش مهمی در تأیید فرمولاسیون نهایی و پایداری میکروبی محصول دارد.
جهت دریافت خدمات و مشاوره رایگان با نیکوفامد تماس بگیرید.
تست چالش میکروبی چگونه انجام می شود؟
در گام نخست، هدف از آزمون بهصورت دقیق مشخص میشود. این آزمون با هدف ارزیابی اثربخشی سیستم نگهدارنده در محصول نهایی طراحی شده است تا اطمینان حاصل شود که محصول در طول زمان، در برابر رشد میکروارگانیسمها مقاوم باقی میماند. محصول باید به همان شکل نهایی، با بستهبندی اصلی و در شرایط واقعی مصرف مورد آزمون قرار گیرد. همچنین، پیش از شروع کار، نوع و سطح ریسک محصول تعیین میشود.
این ارزیابی شامل بررسی ویژگیهایی مانند نوع مصرف (تکمصرف یا چندمصرف)، ناحیه تماس با بدن، شرایط نگهداری و میزان احتمال آلودگی است. تعیین این موارد برای انتخاب سطح پذیرش (A یا B) در استاندارد ضروری است. تمامی تجهیزات آزمایشگاهی از جمله هود، انکوباتور، ترازوی دقیق و تایمر باید پیش از شروع آزمون کالیبره و تأییدشده باشند.
آمادهسازی مواد و سویههای میکروبی
در این مرحله، ارگانیسمهای شاخص تعیینشده در استاندارد شامل Staphylococcus aureus، Escherichia coli، Pseudomonas aeruginosa، Candida albicans و Aspergillus brasiliensis تهیه میشوند. هر سویه باید از منبع مرجع معتبر تهیه و با استفاده از محیطهای استاندارد مانند TSA برای باکتریها و SDA برای قارچها کشت داده شود.
سپس، خنثیکننده و رقیقکننده مناسب با نوع محصول انتخاب میگردد؛ بهعنوان مثال، برای محصولات چرب یا دارای فاز روغنی، از محیطهایی نظیر D/E Neutralizing Broth یا Letheen Broth استفاده میشود. انتخاب خنثیکننده مناسب اهمیت حیاتی دارد، زیرا باید بتواند اثر نگهدارنده را خنثی کند بدون آنکه خود خاصیت ضدمیکروبی داشته باشد.
تهیه و استانداردسازی سوسپانسیون میکروبی
در این مرحله، هر ارگانیسم از کشت تازه و در فاز رشد لگاریتمی تهیه میشود تا سلولهای فعال و زنده در آزمون به کار روند. سوسپانسیون یکنواختی از هر ارگانیسم آماده و غلظت آن با استفاده از شمارش پلیت یا روش نوری (OD) تنظیم میگردد. مقدار نهایی تلقیح باید بهگونهای باشد که در محصول حدود (10^5) واحد کلنی در هر گرم یا میلیلیتر وجود داشته باشد. این مقدار تراکم اولیه برای ایجاد چالشی قابل اندازهگیری و معتبر در آزمون ضروری است.
اعتبارسنجی خنثیسازی
پیش از اجرای آزمون اصلی، خنثیکننده انتخابی باید از نظر کارایی مورد اعتبارسنجی قرار گیرد. در این آزمون، چند کنترل طراحی میشود: کنترل رشد (ارگانیسم بدون تماس با محصول)، کنترل خنثیسازی (محصول به همراه خنثیکننده و ارگانیسم)، و کنترل سمیّت ماتریکس (محصول بدون خنثیکننده).
هدف از این مرحله، اطمینان از آن است که کاهش شمارش میکروبی در آزمون نهایی ناشی از اثر واقعی سیستم نگهدارنده باشد و نه به دلیل باقیماندن فعالیت نگهدارنده در مرحله شمارش. در صورتی که بازیابی میکروارگانیسمها از خنثیکننده کمتر از حد قابلقبول باشد، باید ترکیب یا روش خنثیسازی اصلاح و مجدداً اعتبارسنجی شود.
تلقیح محصول و زمان صفر (T0)
در این بخش، هر ارگانیسم بهصورت جداگانه در نمونهای مستقل از محصول تلقیح میشود. تلقیح باید در شرایط استریل و با رعایت دقت انجام گیرد تا از ورود آلودگیهای ناخواسته جلوگیری شود. پس از تلقیح، محصول بهآرامی و بدون آسیب به ساختار فیزیکی آن (مانند بافت کرم یا ژل) مخلوط میشود تا میکروارگانیسمها بهصورت یکنواخت در کل محصول توزیع شوند. بلافاصله پس از تلقیح، یک نمونه بهعنوان زمان صفر (T0) برداشت شده و با استفاده از خنثیکننده معتبر، رقیقسازی دهدهی و کشت داده میشود تا غلظت اولیه میکروبی ثبت گردد.
نگهداری بین زمانهای آزمون
پس از تلقیح، نمونهها در شرایط واقعی نگهداری محصول (معمولاً در دمای اتاق و دور از نور مستقیم خورشید) قرار داده میشوند. هدف از این مرحله، شبیهسازی شرایطی است که محصول در طول عمر مصرف خود تجربه میکند. تمامی شرایط محیطی از جمله دما و رطوبت باید بهصورت مستند ثبت شوند. در صورت نیاز، دماهای خاص یا شرایط دیگر مطابق دستورالعمل تولیدکننده محصول اعمال میگردد.
نمونهبرداری در زمانهای مشخص
در فواصل زمانی تعیینشده در استاندارد، یعنی در روزهای 7، 14 و 28 پس از تلقیح، از نمونهها برداشت انجام میشود. در هر برداشت، محصول پیش از نمونهگیری بهآرامی یکنواخت میشود تا توزیع میکروارگانیسمها یکسان باشد. سپس مقدار معینی از نمونه برداشته و فوراً در خنثیکننده معتبر مخلوط میشود تا فعالیت نگهدارنده در هنگام شمارش متوقف گردد.
رقیقسازی، خنثیسازی و کشت
در این مرحله، رقتهای دهدهی از نمونه تهیه میشود و هر رقت بر روی محیط مناسب کشت داده میشود. برای باکتریها معمولاً از روش اسپرد پلیت یا پور پلیت بر روی TSA و برای قارچها از SDA استفاده میگردد. همچنین، در هر سری آزمون، کنترل رشد (برای اطمینان از زنده بودن ارگانیسمها) و کنترل منفی (برای بررسی آلودگی محیطی) اجرا میشود. تمامی نمونهها باید بهصورت موازی و در شرایط استریل انجام شوند تا صحت نتایج تضمین گردد.
انکوباسیون و شمارش کلنیها
پلیتهای تلقیحشده بسته به نوع میکروارگانیسم، در دمای مناسب انکوبه میشوند؛ برای باکتریها معمولاً دمای 30 تا 35 درجه سانتیگراد به مدت 48 تا 72 ساعت و برای قارچها و کپکها دمای 20 تا 25 درجه سانتیگراد به مدت 3 تا 5 روز پیشنهاد میشود. پس از انکوباسیون، کلنیهای قابلشمارش انتخاب و تعداد واحدهای تشکیلدهنده کلنی (CFU) در هر گرم یا میلیلیتر محاسبه میشود. دادهها باید با در نظر گرفتن ضرایب رقت و محدودۀ شمارش معتبر ثبت شوند.
محاسبه و تفسیر نتایج
برای هر ارگانیسم، میزان کاهش جمعیت میکروبی در هر زمان نسبت به زمان صفر محاسبه میشود. این کاهش معمولاً بهصورت لگاریتمی بیان میشود و بر اساس رابطهی Log Reduction = log₁₀(N₀) – log₁₀(Nt) محاسبه میگردد، که در آن N₀ شمارش اولیه و Nt شمارش در زمان t است.
در مواردی که رشد مشاهده نشود، از حد تشخیص روش برای برآورد محافظهکارانه استفاده میشود. سپس نتایج با معیارهای پذیرش تعیینشده در استاندارد مقایسه میگردد. سطح A نشاندهنده کارایی بالای نگهدارنده است و معمولاً برای محصولات چندمصرف یا پرریسک الزامی است، در حالیکه سطح B معیار حداقلی و مخصوص محصولات کمریسک است.
مستندسازی و تصمیمگیری نهایی
در پایان آزمون، تمامی دادههای خام، محاسبات، منحنیهای کاهش، نتایج کنترلها و اطلاعات آزمون شامل شناسه محصول، شماره بچ، تاریخها، تجهیزات و شرایط محیطی باید بهطور کامل مستندسازی شود. چنانچه نتایج بهطور کامل با معیارهای سطح انتخابشده همخوانی داشته باشند، محصول از نظر اثربخشی سیستم نگهدارنده تأیید میشود.
در غیر این صورت، لازم است فرمولاسیون، نوع یا غلظت نگهدارنده، pH، میزان آب آزاد (aw) یا حتی نوع بستهبندی مورد بازنگری قرار گیرد و آزمون تکرار شود.
برای آشنایی با انواع آزمون های میکروبی کلیک کنید.
اهمیت آزمون چالش میکروبی (Challenge Test)
تضمین ایمنی میکروبی محصول
هدف اصلی انجام آزمون چالش، تأیید توانایی سیستم نگهدارنده در کنترل یا نابودی آلودگیهای میکروبی احتمالی در طول چرخه عمر محصول است.
محصولات آرایشی و بهداشتی غالباً حاوی مقدار قابلتوجهی آب و مواد مغذی هستند که میتوانند محیطی مناسب برای رشد باکتریها، قارچها و کپکها ایجاد کنند. بدون وجود سیستم نگهدارندهی مؤثر، رشد میکروارگانیسمها میتواند منجر به:
- فساد محصول (تغییر رنگ، بو، ویسکوزیته یا فاز)
- از بین رفتن اثر عملکردی (مثلاً در کرمهای درمانی)
- و در نهایت خطرات بهداشتی برای مصرفکننده (مانند عفونتهای پوستی یا چشمی) شود.
آزمون چالش در واقع یک شبیهسازی کنترلشده از این خطر است تا بررسی شود آیا محصول میتواند در شرایط واقعی، در برابر آلودگی مقاومت کند یا خیر.
ارزیابی کارایی واقعی سیستم نگهدارنده در ماتریکس نهایی
قدرت نگهدارندهها (preservatives) تنها در محیطهای آزمایشگاهی ساده ارزیابی نمیشود؛ بلکه در ماتریکس واقعی محصول باید بررسی گردد.
مواد فرمولاسیون مانند امولسیفایرها، چربیها، پلیمرها یا اسانسها میتوانند بر دسترسی شیمیایی نگهدارندهها به میکروارگانیسمها تأثیر بگذارند (پدیده “preservative binding”).
به همین دلیل، انجام آزمون چالش در فرمول نهایی ضروری است تا نشان دهد نگهدارنده در حضور سایر اجزا همچنان فعال و مؤثر باقی مانده است.
تأیید پایداری سیستم نگهدارنده در طول عمر مفید محصول
نگهدارندهها ممکن است در طول زمان تجزیه شیمیایی، تبخیر یا غیرفعال شوند (بهویژه در دما و رطوبت بالا). آزمون چالش با سنجش کاهش جمعیت میکروبی در چندین نقطه زمانی (۰، ۷، ۱۴ و ۲۸ روز)، پایداری عملکرد نگهدارنده را در طول دوره نگهداری بررسی میکند. این موضوع برای تعیین تاریخ انقضا و شرایط نگهداری ایمن حیاتی است.
ارزیابی ریسک و طراحی بستهبندی
دادههای حاصل از آزمون چالش در ارزیابی ریسک میکروبی محصول (Microbiological Risk Assessment) استفاده میشود.
برای مثال:
- محصول چندبار مصرف در بستهبندی باز → نیازمند سیستم نگهدارنده قویتر (سطح پذیرش A)
محصول تکبار مصرف یا بستهبندی airless → ممکن است سطح پذیرش B کفایت کند.
بنابراین نتایج آزمون چالش مستقیماً در انتخاب نوع بستهبندی و استراتژی نگهدارنده تأثیرگذار است.
بهینهسازی فرمولاسیون و کاهش وابستگی به مواد نگهدارنده قوی
با افزایش نگرانی مصرفکنندگان نسبت به ترکیبات شیمیایی، تولیدکنندگان به سمت استفاده از نگهدارندههای ملایمتر یا طبیعی گرایش دارند. آزمون چالش، ابزار کلیدی برای تعیین حداقل غلظت مؤثر نگهدارنده و بررسی اثر سینرژیک با سایر اجزای فرمول (مثل pH پایین، آبفعال کم یا سیستمهای بستهبندی airless) است.
در نتیجه، این تست به تیم تحقیق و توسعه کمک میکند تا:
- سیستم نگهدارندهای ایمن، کمتحریک و در عین حال مؤثر طراحی کنند.
- و فرمول را با مقررات «clean beauty» و استانداردهای ارگانیک سازگار سازند.
برای آشنایی با آزمون بایوبردن کلیک کنید.
تفاوت آزمون چالش میکروبی و آزمون توان نگهدارندگی
| ردیف | ویژگی مقایسهای | آزمون چالش میکروبی (Challenge Test) | آزمون توان نگهدارندگی (Preservative Capacity / Efficacy Test) |
|---|---|---|---|
| 1 | هدف اصلی | ارزیابی عملکرد واقعی سیستم نگهدارنده در فرمول نهایی محصول در برابر آلودگیهای احتمالی در طول نگهداری و مصرف | سنجش قدرت ذاتی یا پتانسیل ضدمیکروبی مواد نگهدارنده در شرایط کنترلشده و سادهتر (معمولاً در مرحله تحقیق و توسعه) |
| 2 | مرحله استفاده در چرخه توسعه محصول | در مرحله نهایی فرمولاسیون و پیش از عرضه محصول به بازار | در مراحل تحقیقاتی یا طراحی اولیه فرمول برای انتخاب نوع و غلظت نگهدارنده مناسب |
| 3 | ماتریکس آزمون | فرمول نهایی واقعی محصول (همان ترکیب نهایی شامل تمام مواد، pH و بافت اصلی) | معمولاً در محیط سادهتر (محلول آبی یا مدل شبیهسازیشده) بدون تأثیر پیچیده ماتریکس اصلی |
| 4 | پایه استاندارد | ISO 11930:2019، USP <51>، Ph. Eur. 5.1.3 | روشهای داخلی (in-house methods)، خطوط راهنمای صنعتی (مثلاً CTFA، CIR)، یا آزمونهای غربالگری آزمایشگاهی |
| 5 | نوع آلودگی ایجادشده | تلقیح مستقیم محصول با سویههای میکروبی مرجع (S. aureus, E. coli, P. aeruginosa, C. albicans, A. brasiliensis) | معمولاً با تعداد کمتر یا تنوع محدودتر از سویهها، گاهی حتی یک گونه شاخص |
| 6 | پارامترهای ارزیابی | کاهش لگاریتمی بار میکروبی در زمانهای 0، 7، 14، 28 روز (Log Reduction) و مقایسه با معیارهای پذیرش A و B | تعیین زمان نابودی یا مهار رشد میکروبی (MIC، MBC یا زمان مرگ 90٪) در غلظتهای مختلف نگهدارنده |
| 7 | ماهیت آزمون | آزمون تأییدی و تنظیمی (Regulatory Test) | آزمون تحلیلی و تحقیقاتی (Screening/Optimization Test) |
| 8 | خروجی نهایی | تأیید ایمنی میکروبی و انطباق با مقررات (مدرک الزامی برای پرونده محصول) | اطلاعات اولیه برای انتخاب نوع و مقدار نگهدارنده مناسب در فرمول |
| 9 | الزام قانونی | اجباری برای تمام محصولات آرایشی و بهداشتی چندمصرف یا دارای فاز آبی | اختیاری؛ برای بهینهسازی فرمول یا بررسی پایداری نگهدارنده |
| 10 | کاربرد نتایج | ارائه در پرونده ایمنی محصول (Product Information File / PIF) و ممیزیهای GMP | استفاده داخلی تیم تحقیق و توسعه برای اصلاح یا کاهش دوز نگهدارنده |
جمعبندی
آزمون چالش میکروبی یک آزمون تأییدی و نهایی است که بر اساس استانداردهای بینالمللی انجام میشود و هدف آن تضمین ایمنی میکروبی محصول آماده مصرف است.
در مقابل، آزمون توان نگهدارندگی بیشتر جنبه تحقیقاتی و طراحی فرمولاسیون دارد و به تولیدکننده کمک میکند نوع و مقدار بهینه نگهدارنده را پیش از انجام آزمون رسمی ISO یا USP تعیین کند.
آزمایشگاه همکار نیکوفارمد با بهرهگیری از تجهیزات پیشرفته و پرسنل متخصص در حوزه میکروبیولوژی صنعتی، آزمون چالش میکروبی (Challenge Test) را مطابق با استاندارد بینالمللی و الزامات سازمان غذا و دارو انجام میدهد.
آزمایشگاه نیکوفارمد، تمامی مراحل از آمادهسازی سویههای استاندارد تا تفسیر نتایج با دقت علمی بالا و بر اساس روشهای اعتبارسنجیشده انجام میگیرد و به تولیدکنندگان کمک میکند تا با اطمینان از کارایی سیستم نگهدارنده و انطباق با الزامات قانونی داخلی و بینالمللی، محصولات خود را با کیفیت و ایمنی بالاتر به بازار عرضه کنند.